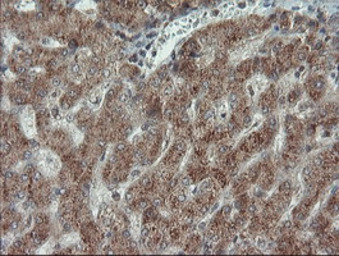
产品细节图片13

相关产品推荐更多 >
万千商家帮你免费找货
0 人在求购买到急需产品
- 详细信息
- 文献和实验
- 技术资料
- 免疫原:
Full-length protein expressed in 293T cell transfected with human SILV expression vector
- 亚型:
IgG2b
- 形态:
Liquid
- 保存条件:
Store as concentrated solution. Centrifuge briefly prior to opening vial. For short-term storage (1-2 weeks), store at 4ºC. For long-term storage, aliquot and store at -20ºC or below. Avoid multiple freeze-thaw cycles.
- 克隆性:
Monoclonal
- 标记物:
Unconjugated
- 适应物种:
Human, Rat, Dog, Monkey
- 保质期:
12 months from the shipping date of the product.
- 抗原来源:
Human
- 目录编号:
GTX83640
- 级别:
Primary Antibodies
- 库存:
Available
- 供应商:
GeneTex
- 宿主:
Mouse
- 应用范围:
WB, ICC/IF, IHC-P
- 浓度:
1 mg/ml (Please refer to the vial label for the specific concentration.)
- 靶点:
Melanoma gp100
- 抗体英文名:
Melanoma gp100 antibody [8A4]
- 抗体名:
Melanoma gp100 抗体 [8A4]
- 规格:
100 μl

IHC-P analysis of human ovary adenocarcinoma tissue using GTX83640 Melanoma gp100 antibody [8A4].

IHC-P analysis of human pancreas tissue using GTX83640 Melanoma gp100 antibody [8A4].

IHC-P analysis of human bladder carcinoma tissue using GTX83640 Melanoma gp100 antibody [8A4].

WB analysis of HEK293T cells transfected with Melanoma gp100 plasmid (Right) or empty vector (Left) for 48 hrs using GTX83640 Melanoma gp100 antibody [8A4].
Loading : 5 ug per lane

IHC-P analysis of human endometrium adenocarcinoma tissue using GTX83640 Melanoma gp100 antibody [8A4].

IHC-P analysis of human tonsil tissue using GTX83640 Melanoma gp100 antibody [8A4].

WB analysis of various cell lines using GTX83640 Melanoma gp100 antibody [8A4].
Loading : 35 ug per lane

IHC-P analysis of human prostate tissue using GTX83640 Melanoma gp100 antibody [8A4].

ICC/IF analysis of A549 cells using GTX83640 Melanoma gp100 antibody [8A4].

IHC-P analysis of human prostate carcinoma tissue using GTX83640 Melanoma gp100 antibody [8A4].

ICC/IF analysis of COS7 cells transiently transfected with Melanoma gp100 plasmid using GTX83640 Melanoma gp100 antibody [8A4].

IHC-P analysis of human pancreas carcinoma tissue using GTX83640 Melanoma gp100 antibody [8A4].
IHC-P analysis of human liver tissue using GTX83640 Melanoma gp100 antibody [8A4].
风险提示:丁香通仅作为第三方平台,为商家信息发布提供平台空间。用户咨询产品时请注意保护个人信息及财产安全,合理判断,谨慎选购商品,商家和用户对交易行为负责。对于医疗器械类产品,请先查证核实企业经营资质和医疗器械产品注册证情况。
 文献和实验
文献和实验Nat Med:个体化肿瘤疫苗突破,特异性 T 细胞持续 4.5 年,患者存活率 100%
方面的结果如何呢? 2021 年 1 月 21 日,来自美国 Dana-Farber 癌症研究所的 Catherine J. Wu 团队在 Nature Medicine 上发表了题为 Personal neoantigen vaccines induce persistent memory T cell responses and epitope spreading in patients with melanoma 的文章 [1],向世界宣布了一项令人兴奋的临床试验结果:8 名恶性黑色素瘤患者
Nature 综述导读:FDA 批准第 100 个抗体药物!抗体药物的研究方向在哪里?
批准了第 50 种抗体,距离第一个抗体已经过去了 29 年。2021 年 4 月,随着葛兰素史克 PD1 阻断剂 dostarlimab 的批准,抗体药物仅用了 6 年多的时间就达到了 100 个,进入了「百抗」新时代(图五)。 图五 Nature Reviews Drug Discovery 20, 10 (2021) 上面提到的 100 个抗体并不是单纯经典的单克隆的裸抗体(naked antibody),其中也包括了抗体片段已经工程化修饰抗体的各种偶联形式。其中包括有抗体药物偶联(ADC
【转帖】Top 100 proteomics publications
Top 100 proteomics publications ----From Ion Channel Media Group:ttp://www.ionchannelmedia.com/websites.php 1. Gavin et al. (2006) Proteome survey reveals modularity of the yeast cell machinery. Nature 2. Bonetta et al. (2006) Protein
 技术资料
技术资料暂无技术资料 索取技术资料







![SSEA-1 / CD15 antibody [FUT4/1478R]](https://img1.dxycdn.com/2022/0328/782/0980186194510700453-14.jpg!wh200)



